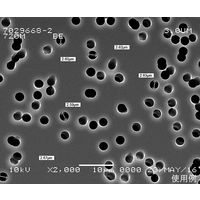
Track Etched Membrane， Polycarbonate， 47mm， 8um， 100/pk 1215637（直送品）

「PK-8」の特集
「PK-8」の特集ページはこちら。生活雑貨/キッチン用品に関連する商品も豊富に取り揃えています。アスクルは、オフィス用品/現場用品の法人向け通販です。
「PK-8」の検索ワードに該当する商品を50件表示しています
「PK-8」に関するピンポイントサーチ
-

スプーン プラ
やなぎプロダクツ プラスチックスプーン 16cm 単袋入 517097 3000本(100本×30)(直送品)ほか人気商品が選べる!
-

ケース ビーズ
明邦化学工業 メイホー ビーズトレー 5枚入 BT 1セット(1800枚:5枚×360パック) 735-8300(直送品)などのオススメ品が見つかる!
-

クリアフォーク
MISM PSデザートスプーン クリア M 1000本 1セット(1袋×10)(直送品)といったお買い得商品が勢ぞろい。
-

プラスプーン
やなぎプロダクツ プラスチックスプーン 16cm 単袋入 517097 3000本(100本×30)(直送品)など目白押しアイテムがいっぱい。
-

スプーン WA
オリヂナル オリヂナル薬湯 しょうが 4901180026155 1個(750G)(直送品)を要チェック!
-

フォー プロ
やなぎプロダクツ プラスチックスプーン 16cm 単袋入 517097 3000本(100本×30)(直送品)などの売れ筋商品をご用意してます。
-

ケース FD
M-Lockケース FD1001TL10WT ホワイト10枚 1パック ナガセテクノサービス(直送品)ほか人気商品が選べる!
-

FD160
中央化学 使い捨てカトラリー FDフォーク 160 単袋入 642959 1ケース(2000個(100個×20))(直送品)などのオススメ品が見つかる!
-

FDケース
M-Lockケース FD1001TL10WT ホワイト10枚 1パック ナガセテクノサービス(直送品)といったお買い得商品が勢ぞろい。
-

カトラリー
エムズジャパン 天目塗分箸置 T03-174 1個 62-6728-71(直送品)など目白押しアイテムがいっぱい。
-

ナイフケース
遠藤商事 プラシルバー プチスプーン (40本入) B-S-002 1ケース(40本) 62-6679-38(直送品)を要チェック!
-

ケースナイフ
遠藤商事 プラシルバー プチスプーン (40本入) B-S-002 1ケース(40本) 62-6679-38(直送品)などの売れ筋商品をご用意してます。
-

きり たん
スリッパ 使い切り 前あき 使い切り不織布スリッパ エコノミータイプ ホワイト 1箱(300足入) オリジナルほか人気商品が選べる!
-

フラワー
やなぎプロダクツ フラワーガーデン植林元禄箸100膳 袋入 1パック(直送品)などのオススメ品が見つかる!
-

B-62
日電理化硝子 ゴム栓(ブチル) 凍結乾燥用・Bタイプ 大 25個入 309018 1袋(25個) 62-9979-19(直送品)といったお買い得商品が勢ぞろい。
-

236E
大同端子製造 DST フェルール形端子用工具(シングル 6~16sq) HT-236E1 1丁 369-8484(直送品)など目白押しアイテムがいっぱい。
-

かんざし
のぼり屋工房 ポール横棒 通常タイプ 595 1本 65-0383-29(直送品)を要チェック!
-

おまけ
【うがい薬】 パブロンうがい薬C 470mL 1ケース(20本:1本×20) 大正製薬などの売れ筋商品をご用意してます。
-

オコメ
紺屋商事 ダンボール 産地直送お米10kg みかん6kg用 10枚入 01150015 1セット(10枚) 65-1674-33(直送品)ほか人気商品が選べる!
-

おこめ
紺屋商事 ダンボール 産地直送お米10kg みかん6kg用 10枚入 01150015 1セット(10枚) 65-1674-33(直送品)などのオススメ品が見つかる!
-

えび
トラスコ中山 TRUSCO フェイクレザー前開きスリッパ フリーサイズ ブラック FLSL-BK 1足 208-5171(直送品)といったお買い得商品が勢ぞろい。
-

つまようじ
シンワ つまようじ2個パック 1パック(直送品)など目白押しアイテムがいっぱい。
-

わりばし
やなぎプロダクツ 割箸 ベトナム植林元禄箸 500膳入 VI-029 1袋(直送品)を要チェック!
-

おはし
やなぎプロダクツ 竹天削割箸 20.8cm 1箱(3000膳)などの売れ筋商品をご用意してます。
-

はし
タニタ 血圧計 手首式 ホワイト BP-A11-WH 1セット(2台)ほか人気商品が選べる!
-

ピック
二ノ宮クリスタル クリスタルピック DGー20090(100本入) 61-6805-44 1組(100本)(直送品)などのオススメ品が見つかる!
紙コップ/紙おしぼり/割り箸/使い捨て容器に関するピンポイントサーチ一覧へ
「PK-8」をメーカーで絞り込む
- ARC
- Elemental Microanalysis
- GVS
- IDEX
- やなぎプロダクツ
- アサヒグリーン
- アサヒ徳島
- アズワン
- イシハシ精工
- イデシギョー
- エフピコ
- カウパック
- カネヨ石鹸
- サラヤ
- サンコーインダストリー
- ショーワグローブ
- スーパーメイト
- デンカポリマー
- トラスコ中山
- トーダイ
- ドリテック
- ナカバヤシ
- ニチバン
- ニチフ端子工業
- プーキートレーディング
- マルアイ
- ミツヤ
- メルク
- ヤマト産業
- ワゴジャパン
- 三好キカイ
- 京都機械工具
- 光
- 北村製作所
- 友屋
- 大和物産
- 安全興業
- 小林製薬
- 新富士バーナー
- 日本ファイリング
- 日本メディカルプロダクツ
- 日本製紙クレシア
- 旭創業
- 東罐興業
- 水本機械製作所
- 福助工業
- 萬洋
- 酒井容器
- 鹿島化学金属
- UHT









![京都機械工具 KTC ノックピンポンチセット[8本組] PK8 1セット 373-7241(直送品)](http://cdn.askul.co.jp/img/product/L1/5544918_l1.jpg)